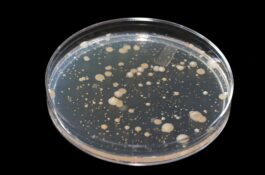

Vooral ouderen, zwangeren en mensen met een broze gezondheid of onderliggende aandoening moeten uitkijken met het drinken van besmet kraanwater in Utrecht, zo luidde de waarschuwing van het waterbedrijf en gezondheidsinstanties. Huisartsen kregen opvallend weinig patiënten met klachten aan hun balie op één praktijk na waar het wel druk was, zo bericht het Algemeen Dagblad. […]